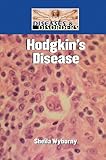
Amazon cover image

Hodgkin's disease / Sheila Wyborny
Series: Diseases & DisordersPublication details: Detroit : Lucent Books, 2009Description: 104 p. : ill. ; 24 cmISBN:- 9781590186749 (hardcover)
- WH500
| Item type | Current library | Home library | Call number | Materials specified | Copy number | Status | Date due | Barcode | |
|---|---|---|---|---|---|---|---|---|---|
| AM | PERPUSTAKAAN HOSPITAL CANSELOR TUANKU MUHRIZ | PERPUSTAKAAN HOSPITAL CANSELOR TUANKU MUHRIZ KOLEKSI AM-P. HOSPITAL CANSELOR TUANKU MUHRIZ | WH500.W974h 2009 9HUKM (Browse shelf(Opens below)) | n.1 | 1 | Available | 00001569755 | ||
| AM | PERPUSTAKAAN HOSPITAL CANSELOR TUANKU MUHRIZ | PERPUSTAKAAN HOSPITAL CANSELOR TUANKU MUHRIZ KOLEKSI AM-P. HOSPITAL CANSELOR TUANKU MUHRIZ | WH500.W974h 2009 9HUKM (Browse shelf(Opens below)) | n.2 | 1 | Available | 00001570034 | ||
| AM | PERPUSTAKAAN HOSPITAL CANSELOR TUANKU MUHRIZ | PERPUSTAKAAN HOSPITAL CANSELOR TUANKU MUHRIZ TELUK INTAN-P. HOSPITAL CANSELOR TUANKU MUHRIZ | WH500.W974h 2009 9HUKMTL (Browse shelf(Opens below)) | 1 | Available | 00001569882 |
There are no comments on this title.
Log in to your account to post a comment.